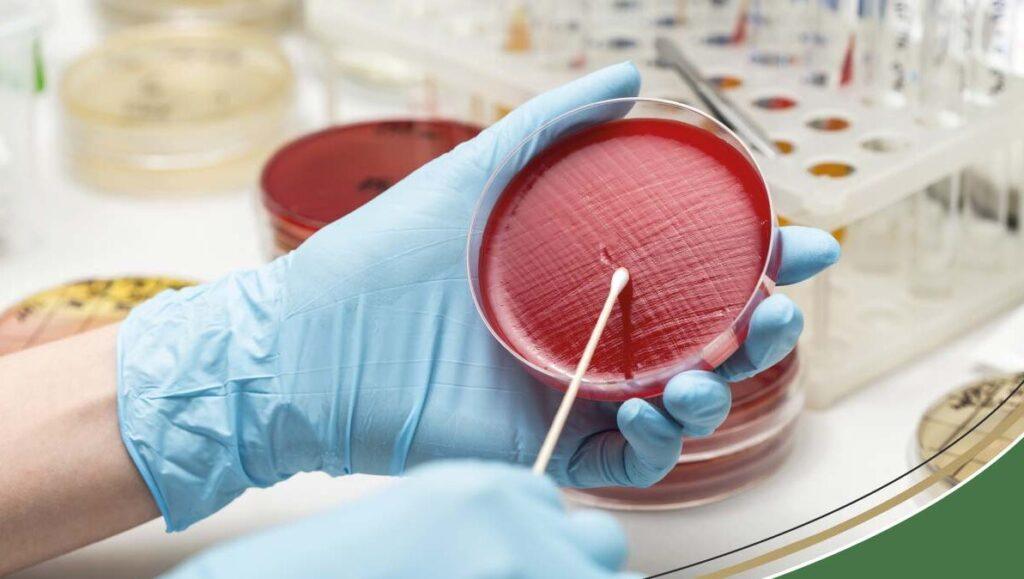

Collecting a proper urine sample for culture helps your doctor identify infections accurately and avoid false results. A clean, midstream sample in a sterile container is the gold standard for most people.[1][2]
Before you start
- Use the sterile container given by your lab or clinic; do not reuse bottles from home.[4]
- Wash your hands thoroughly with soap and water, then dry them with a clean towel.[2]
- Ideally collect the first morning urine or after at least four hours without urinating, as this makes germs easier to detect.[4]
Cleaning the area
- For people with a penis: pull back the foreskin if present and wash the tip with clean water or wipes from front to back.[2]
- For people with a vulva: spread the labia and clean from front to back, repeating with fresh wipes as directed.[2]
- Dry gently with clean tissue; this step reduces contamination from skin bacteria.[3]
Taking the midstream sample
- Begin urinating into the toilet and let the first few seconds pass to flush the urethra.[7]
- Without stopping the flow, move the container into the stream and collect urine to about one‑third to two‑thirds full.[4]
- Remove the container before you finish urinating and close the lid tightly without touching the inside surfaces.[1]
After collection
- Label the container with your name, date, and time if the lab has not already done so.[5]
- Deliver the sample to the laboratory within one to two hours; if there is a delay, keep it in the refrigerator as advised.[16]
- Follow any extra instructions given by your healthcare provider, especially if you use catheters or are helping a child.[11]